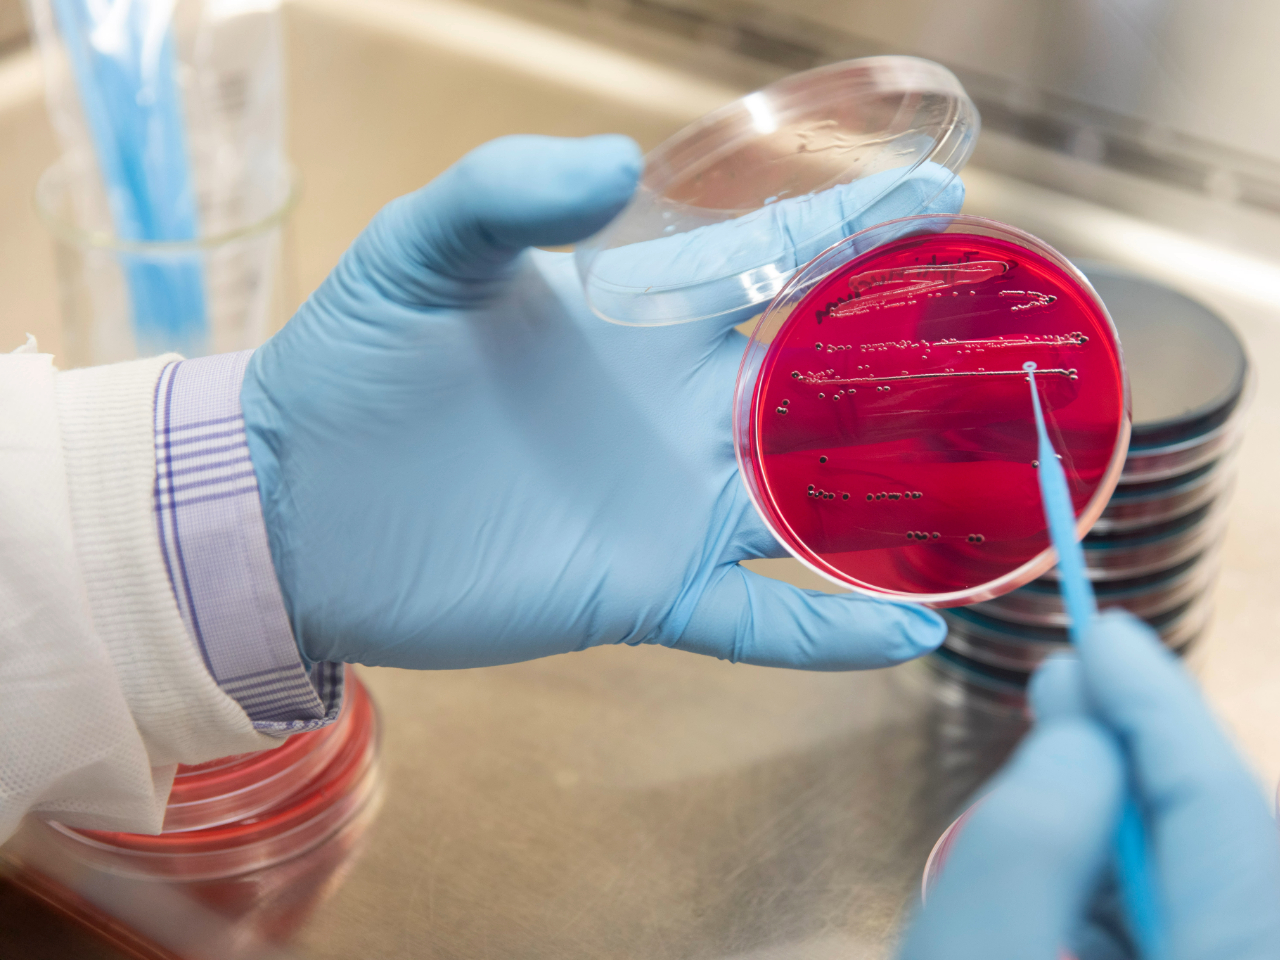
Tissue Culture Plates

We use a lot of single-use plastics in research—Urbina et al estimated in Nature (2015) that biosciences are responsible for over 5.5 M metric tons of plastic waste annually. Experts believe this number is likely much higher today considering the increase in our use of plastics.
The UGA Green Labs program, in partnership with Waste Reduction Services, strives to divert these materials from the landfill and is currently building and expanding campus laboratory recycling efforts. See the Plastic Lab Waste Streams section below for the current state of recycling for each item.
An institutionalized laboratory recycling pilot is currently underway on campus and will be expanded to include other buildings after the trial period is successfully completed.
NO lab items can be placed in the single-stream recycling on UGA campus.